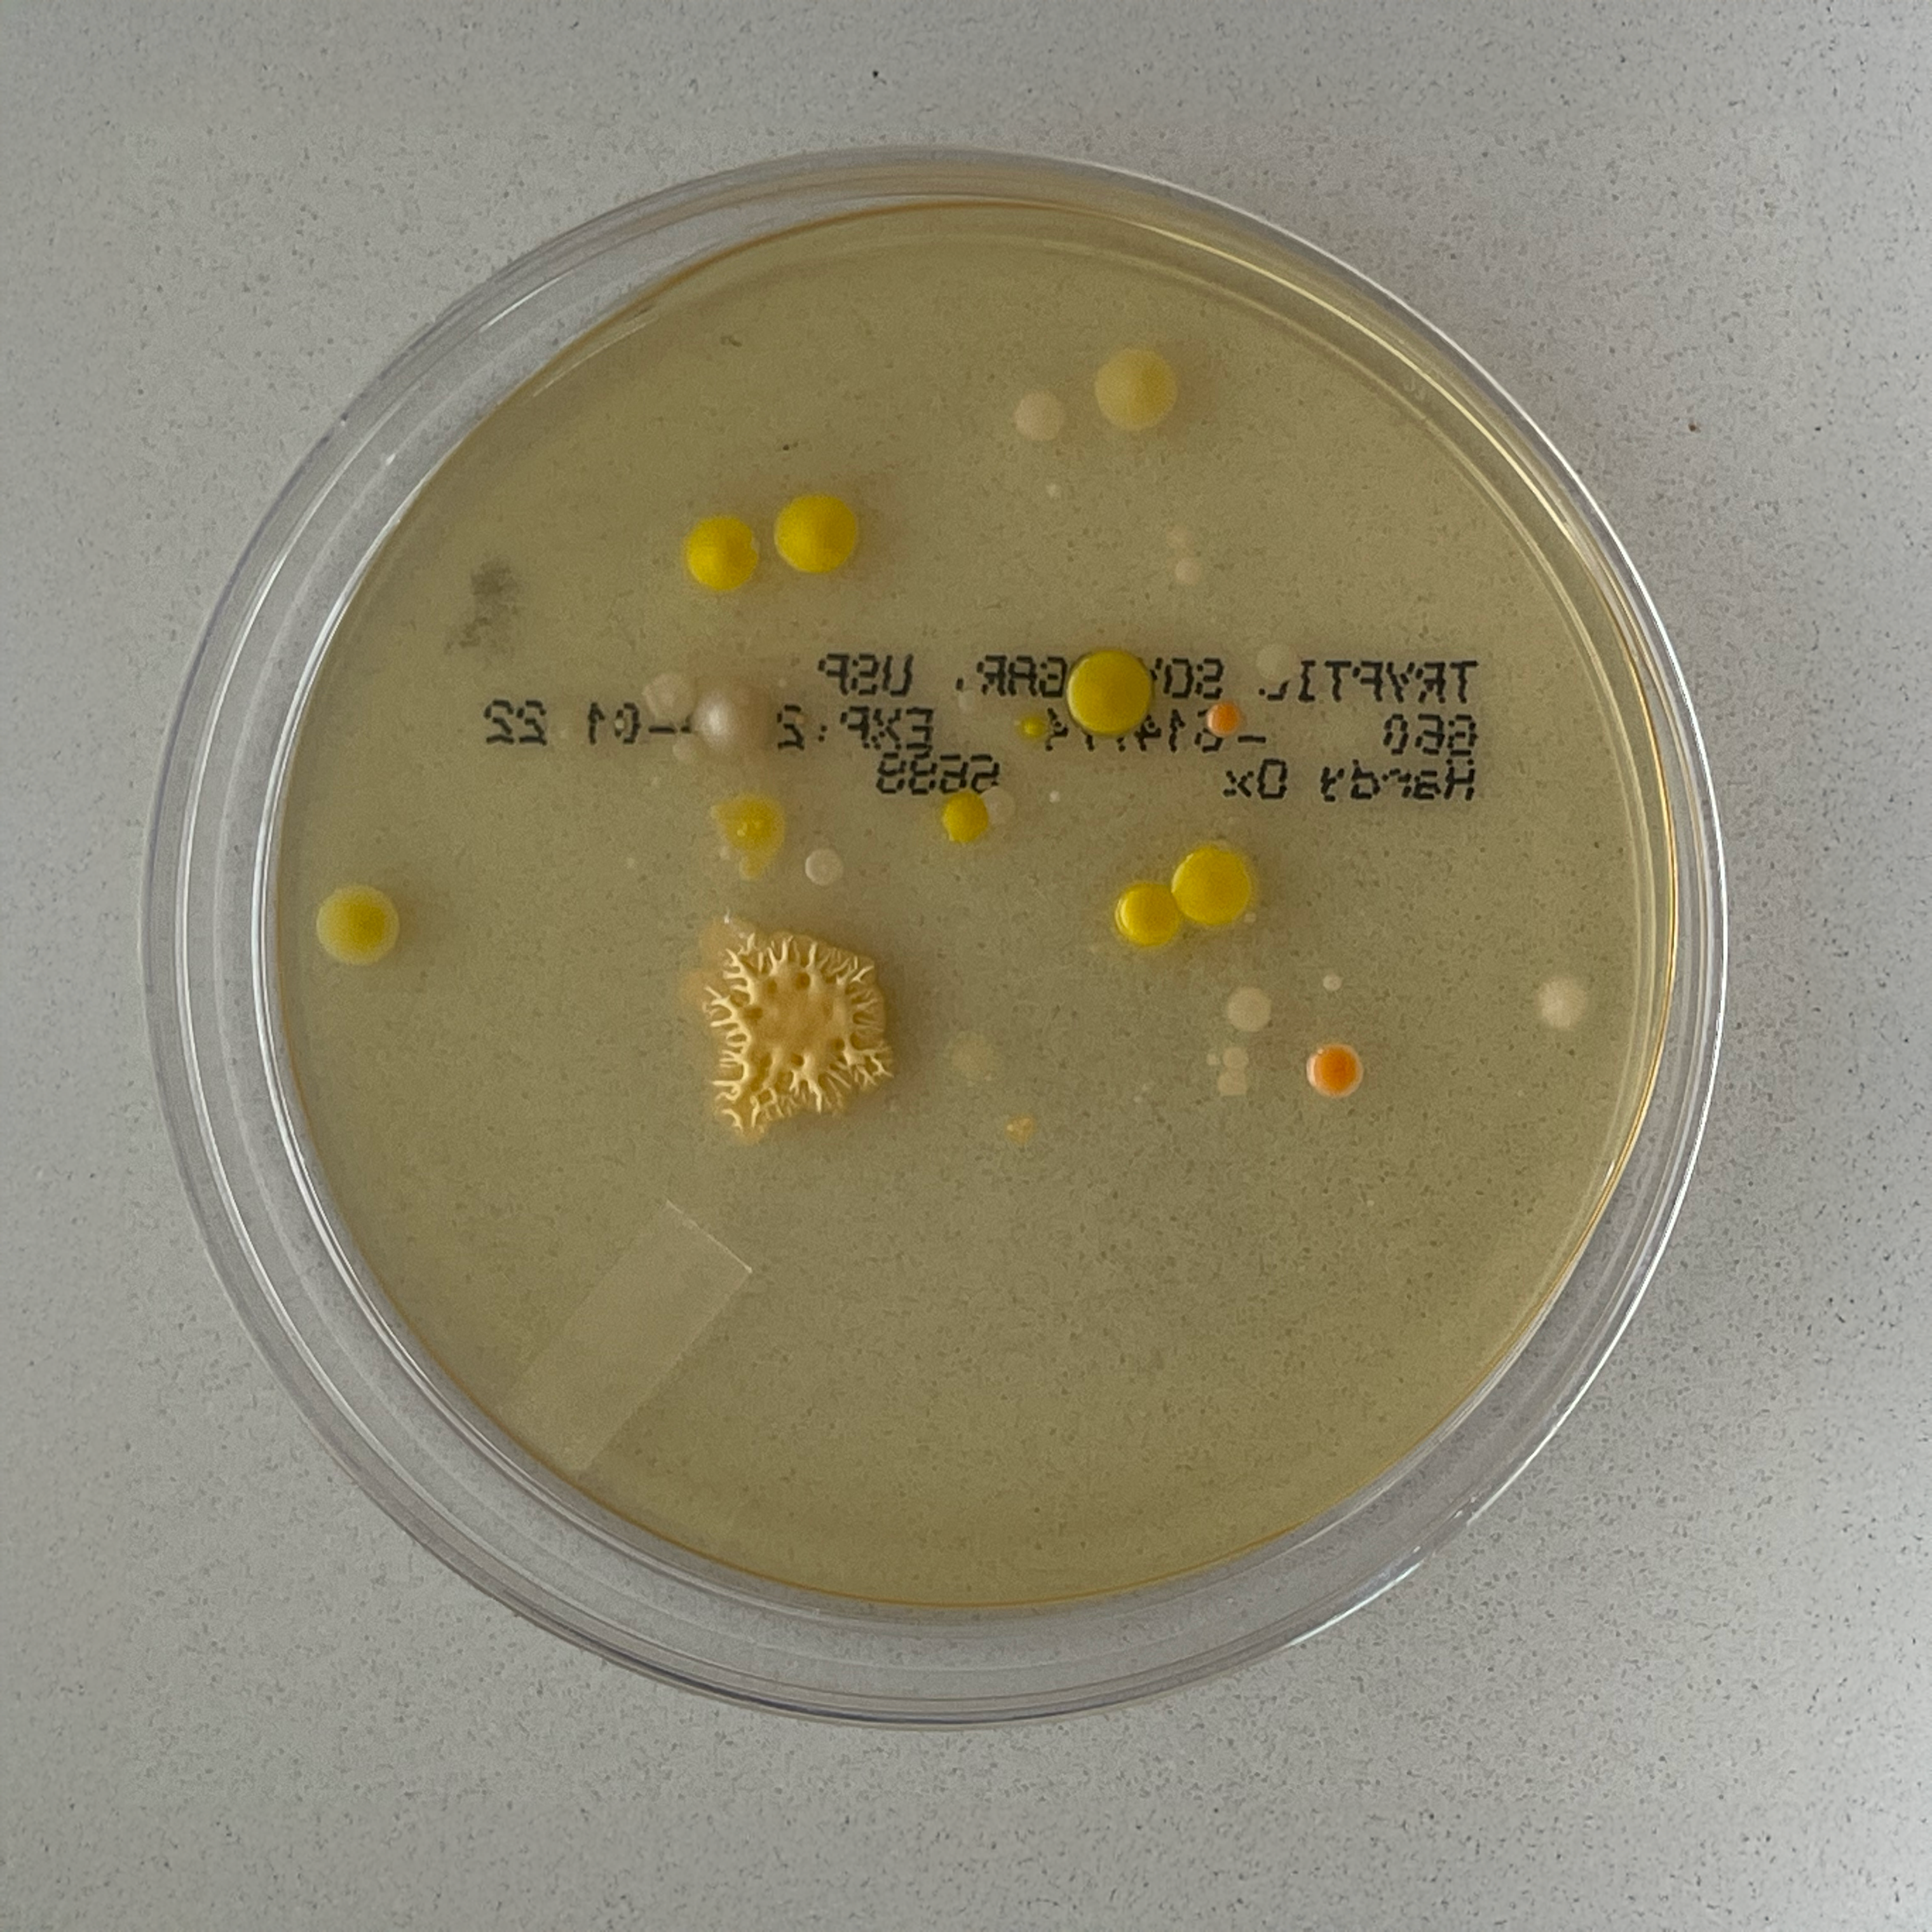
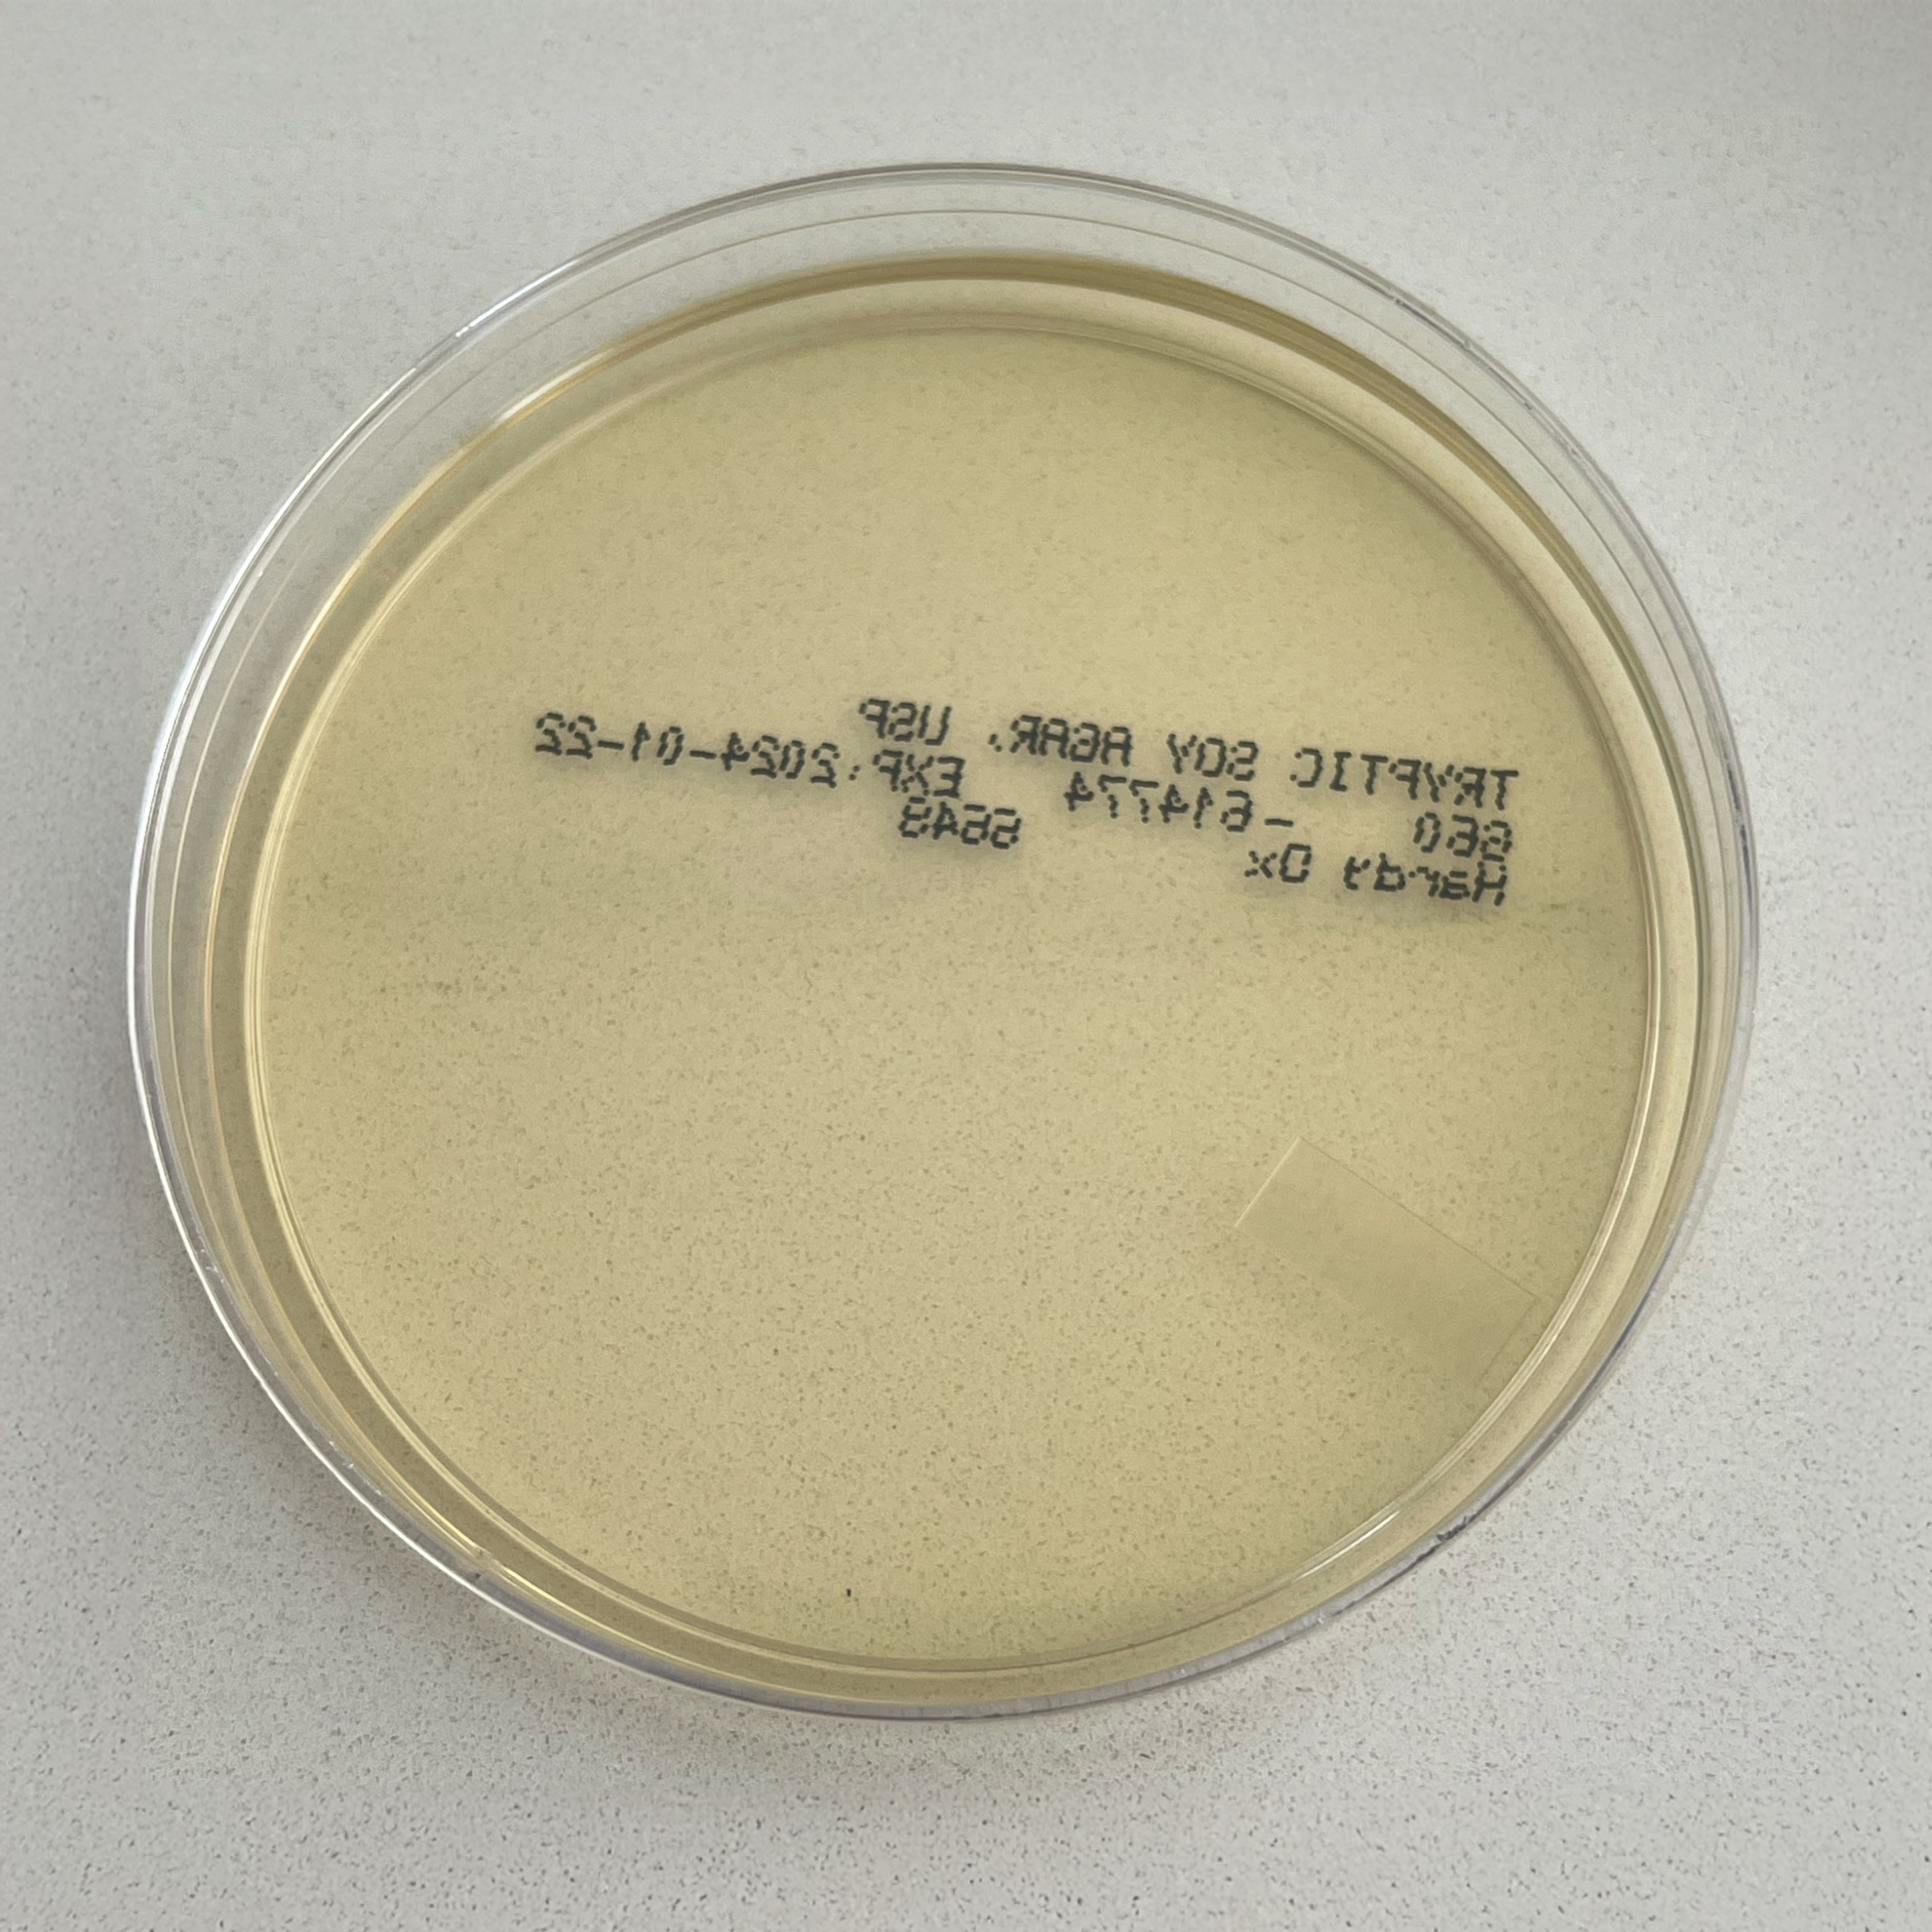

when it comes to skincare, the tools you use are just as important as the products themselves. Your towel, for example, is a key player in your daily routine—but how clean is it, really?
when it comes to skincare, the tools you use are just as important as the products themselves. Your towel, for example, is a key player in your daily routine—but how clean is it, really?